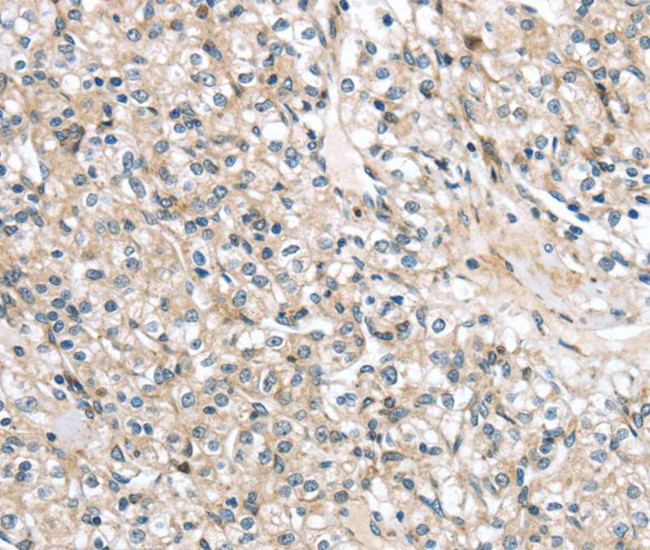
TMPRSS11B Antibody in Immunohistochemistry (Paraffin) (IHC (P))

Search
Invitrogen
TMPRSS11B Polyclonal Antibody
{{$productOrderCtrl.translations['antibody.pdp.commerceCard.promotion.promotions']}}
{{$productOrderCtrl.translations['antibody.pdp.commerceCard.promotion.viewpromo']}}
{{$productOrderCtrl.translations['antibody.pdp.commerceCard.promotion.promocode']}}: {{promo.promoCode}} {{promo.promoTitle}} {{promo.promoDescription}}. {{$productOrderCtrl.translations['antibody.pdp.commerceCard.promotion.learnmore']}}

Please note: We are reviewing Western blot images included in the antibody testing data in our catalog, including those provided by third parties. Unless expressly labeled or annotated as “raw-unedited”, Western blot images included in the antibody testing data in our catalog may have been edited, optimized or otherwise adjusted for presentation.
产品信息
PA5-50811
种属反应
宿主/亚型
分类
类型
抗原
偶联物
形式
浓度
规格
纯化类型
保存液
内含物
保存条件
运输条件
RRID
产品详细信息
The antibody detects endogenous levels of total TMPRSS11B protein.
靶标信息
TMPRSS11B, a member of the transmembrane serine protease family, has recently gained attention for its role in promoting tumor growth, particularly in lung squamous cell carcinomas (LSCCs). This gene is located on chromosome 4q13.2 and encodes a protein involved in proteolytic processing of substrates, impacting cellular communication and tissue homeostasis. TMPRSS11B is upregulated in LSCCs, and its high expression correlates with poor survival rates in non-small cell lung cancer patients. Research has demonstrated that TMPRSS11B facilitates metabolic reprogramming in cancer cells, aiding their transformation and proliferation. In vitro studies with immortalized human bronchial epithelial cells have shown that TMPRSS11B enhances tumor growth, indicating its potential as a therapeutic target for lung cancer treatment. Moreover, TMPRSS11B depletion in immunocompetent mice led to reduced tumor burden and increased infiltration of immune cells, suggesting its influence on the tumor microenvironment.
仅用于科研。不用于诊断过程。未经明确授权不得转售。
篇参考文献 (0)
生物信息学
蛋白别名: Airway trypsin-like protease 5; Transmembrane protease serine 11B
基因别名: HATL5; TMPRSS11B
Entrez Gene ID: (Human) 132724